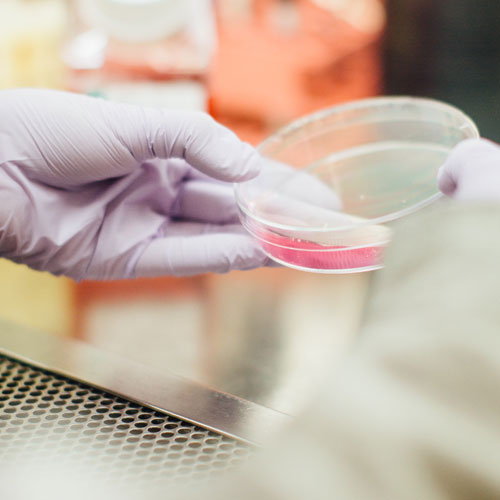

Sourcing personnel for your Quality Assurance and Control team
Our broad consultant network is equipped to supply specialists for every part of your quality management system. We will tap into the active and passive market and exercise a compelling brand story on your behalf to attract consultants from far and wide to their dream Quality job.
Our consultants develop and implement internal processes to ensure that your company’s systems run seamlessly through writing and executing standard operating procedures and performing batch record reviews; developing and implementing quality systems; planning and resolving corrective and preventative actions (CAPAs) and evaluating / executing quality control.
Through a commitment to nurturing the Quality market, we ensure that our consultants embody a technical competency, analytical mindset and demonstrable proficiency in keeping up to date with changing legislation to keep your business compliant. Our consultants’ experience levels range from entry-level to those with the capacity to lead an entire Quality function, encompassing quality execution, automation, management & auditing, systems validation, remediation and production approvals into their remit.
Examples of Quality specialists provided:
- Quality Auditors
- Quality Engineers
- Quality Managers / Directors
- Head of Quality
- Validation Managers
- Specialists in Automation / CSV / QMS / Quality Control / Remediation / Supplier Management
Quality Consulting Services
Considerations within your Quality department
Quality Assurance is a critical part of any Life Science eco-system in ensuring that the research, development, production, and maintenance of products meet applicable regulations, and are optimized for user safety, transparency, and consistency.
Significant investment into the Life Sciences Quality space, coupled with the advances in innovation driving clinical development pipelines forward, necessitate that employers secure increasingly specific levels of specialization in their expertise.
We recognize that there is increasing strain on the quality talent pool and that competition is fierce. Many organizations are adopting a “total quality” approach to enable all facets of their quality considerations to be managed as a single harmonized process, significantly impacting the talent supply chain for many organizations.